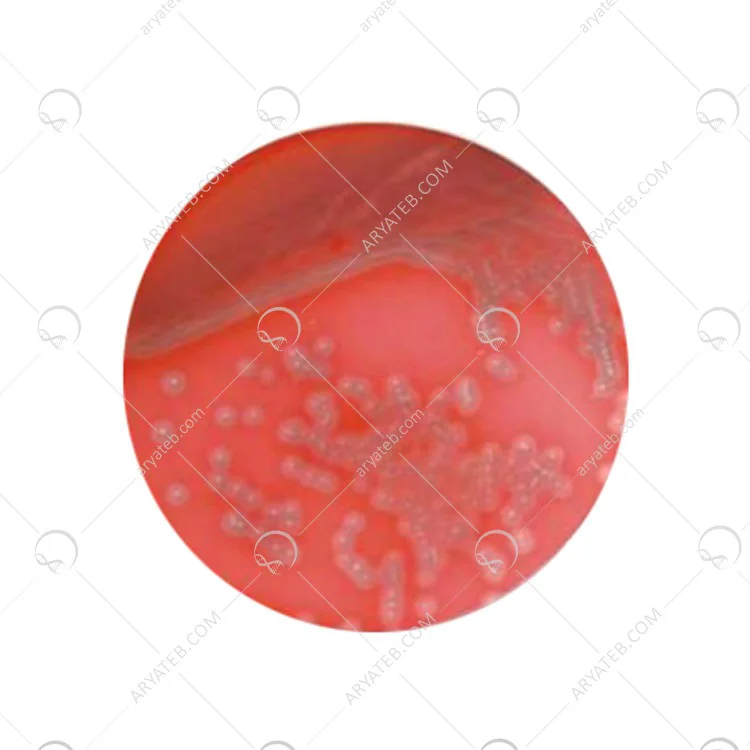

محیط کشت آسپاراژین براث
- برای تجزیه و تحلیل میکروبیولوژی آب های تفریحی از طریق لوله های چندگانه مورد استفاده قرار می گیرد
محیط کشت Asparagine broth
|
عنوان |
آسپاراژین براث |
|
کلمه کلیدی |
آسپاراژین براث |
|
کلمه کلیدی مرتبط |
براث غنی سازی، سودوموناس آئروژینوزا |
|
خلاصه |
آسپاراژین براث یک براث غنی می باشد که برای باکتری های سودوموناس آئروژینوزا استفاده می گردد. این ماده را فقط باید برای مصارف آزمایشگاهی استفاده کرد و در دماین 4 تا 30 درجه ی سانتی گراد نگه داری کرد. باید اضافه کرد که آسپاراژین منبع کربن و اسید امینو نیز می باشد. |
آسپاراژین براث
آسپاراژین براث چیست
آسپاراژین براث یک براث غنی سازی عالی برای سودوموناس آئروژینوزا می باشد. از این ماده زمانی استفاده می شود که می خواهند هیدرولیز کردن آسپاراگین و اسید آسپرتیک باکتری ها را شمارش و یا شناسایی کنند. خوب است بدانید که سودوموناس آئروژینوزا یک بیماری فرصت طلب برای انسان ها محسوب می شود و توانایی رشد در آب با وجود غلظت کمی از مواد مغذی را دارند. به همین علت می باشد که تعداد سودوموناس آئروژینوزای موجود در اب های معدنی طبیعی و آب چشمه بسیار زیاد است.
این میکروارگانیسم را می توانید در آب استخر نیز پیدا کنید. آسپاراژین براث شامل مواد کاملا معدنی با آسپاراژین به عنوان منبع نیتروژن و گلیسرول به عنوان منبع کربن است. به این نکته توجه کنید اگر می خواهید با این براث غنی سازی از لحاظ میکروبیولوژی آب بطری درست کنید، باید از محیط کشت و یا ماده ی اسپاراژین براث استفاده کنید.
آسپاراژین براث برای چه مواردی کاربرد دارد
آسپاراژین براث معمولا برای تجزیه و تحلیل میکروبیولوژی آب های تفریحی از طریق لوله های چندگانه مورد استفاده قرار می گیرد و همچنین یک آزمایش تست پیش فرض می باشد که می توان از آن برای جدا کردن باکتری های گرم منفی غیر تخمیر استفاده کرد.
نحوه ی آماده سازی آسپاراژین براث چگونه است
13.5 گرم پودر را در یک لیتر آب مقطر که حاوی گلیسرول است، حل کنید. مقدار گلیسرول باید 8 میلی لیتر باشد. باید ان را تا 15 دقیقه استریل کنید و در لوله های 10 میلی متری پخش کنید. برای اینکه آسپاراژین براث قدرت دو برابر داشه باشد، می توانید 27 گرم پودر را در یک لیتر آب مقطر مخلوط کنید. در صورتی که می خواهید این ماده قدرت بیشتری داشته باشد باید گلیسرول آن را 16 میلی لیتر کنید.
شما باید این براث غنی سازی را با هم به خوبی مخلوط کنید و باید به ان گرما بدهید. یک دقیقه آن را بجوشانید تا به طور کامل حل گردد. توجه داشته باشید که استریل کردن لوله ها بسیار مهم و ضروری می باشد.
شرایط نگهداری آسپاراژین براث چگونه است
آسپاراژین براث فقط باید در آزمایشگاه استفاده شود و فقط به عنوان براث غنی سازی برای مصارف آزمایشگاهی است. باید بعد از باز شدن ظرف آسپاراژین براث، درب ان محکم بسته شود و در جای خشک و خنک نگهداری شود. سعی کنید آن را از نور خورشید دور نگه دارید. دمای مناسب برای نگهداری این ماده بالای 4 تا 30 درجه ی سانتی گراد است. شما باید به دمای محیطی که آسپاراژین براث در آن وجود دارد توجه ی بسیار زیادی کنید.
شما باید درباره ی ظاهر و رنگ آسپاراژین براث نیز اطلاعاتی داده باشید که ما در ادامه به ان اشاره می کنیم. ظاهر آسپاراژین براث سفید می باشد و همانند پودر خامه ای روان می ماند. اگر بخواهید شفافیت و وضوح این براث غنی سازی را بدانید، باید اضافه کرد که در صورت اماده شدن محلول شفاف، بی رنگ و بدون رسوبی می یاشد.
باید اضافه کرد که آسپاراژین براث نسبت به محیط کشت های دیگر یک محیط کشت بسیار ساده می باشد که حاوی اسید امینو DL- اسپاراژین و دو نمک دیپوتاسیوم فسفات و سولفات منیزیم است. آسپاراژین خود به تنهایی منبع اسید آمینو و کربن میباشد، اما فسفات و سولفات زمینه را برای یون های سودوموناس آئروژینوزا به وجود می اورد.
براث قوی و غنی است که منتخب باکتری های سودوموناس میباشد که فقط مناسب آزمایشگاه است که منبع کربن و اسید آمونیوم میباشد در زمان هیدرولیز کردن آسپاراگین و شمارش باکتری ها کاربرد دارد به عنوان بیماری فرصت لطف در میان انسان ها شناخته شده در حالی که دارنده ی غلظت کمی مواد مغذی میباشد و قادر به تامین کردن نیست میکروارگانیسم آسپاراژین به تعداد بسیار زیادی در آب استخر موجود می باشد که تولید کننده املاح معنی به فشار می آیند .
برای تهیه آب بطری باید از محیط کشت غنی سازی یا آسپاراژین براث استفاده کنید بیشتر در جهت تجزیه و تحلیل میکروبیولوژی آب تفریحی از طریق چندین لوله قادر به استفاده است گاهی درست مانند آزمایش تست باکتری های غیر تخمیری قابل استفاده می باشد که به عنوان جداسازی باکتری های گرم منفی استفاده می گردد .
محیط کشت Asparagine broth
روند تولید این ماده
پودری با آب مقطر حاوی اسانس گلیسرول ترکیب می شود مدت زمان مشخصی را برای استریل کردن انتخاب کنید برای این که قدرت اثرگذاری بالایی پیدا کند میتوانید مواد به کار رفته را افزایش دهید در نهایت براث غنی سازی را با هم ترکیب کنید و در معرض حرارت قرار دهید باید لوله ایی که محتوا درونش می باشد را استریل کنید و بجوشانید.
ظاهراین آسپاراژین براث پودر خامه ای روان اسن که بسیار سفید است برای این که بتوانید شفافیت این براث غنی سازی شده را به آسانی ببینید باید روند تولید گونه ای باشد که محلول شفاف که ابتدا بی رنگ می باشد رسوب نشود در حالی که نسبت به سایر محیط های کشت ساده است آسپاراژین دو مدل نمک دیپوتاسیوم فسفات و سولفات منیزیم می باشد. آسپاراژین خود به تنهایی اسید های آمینو و کربن است.
در میان بیست آمینو اسیدیته شناخته شده که در یاخته های اصلی است اولین کشف شدگی توسط دانشمندان آسپاراژین فرانسوی انجام شد آمینو اسید غیر ضروری می باشد در صورت واکنش قند و آسپاراژین از نوع کاهش بوده که به همراه خود تولید آمینو اکریلیک را تولید میکند .
بیشتر به عنوان حفظ کننده تعادل دستگاه اعصاب مرکزی شناخته شده مانع از هرگونه عصبانیت با شدت یا آرامش محض می باشد.
اسید آمینه فعالیت خود را درون کبد آغاز و همراه خود اسید آمینه دیگری تولید میکند .
دارای فرمول شیمیایی C2H8N2O3 میباشد بیشتر درون مواد غذایی چون مارچوبه ،مرغ و اکثر غذاهای دریایی دیده میشود که باعث پیشرفت و پخش سلول های سرطانی در سراسر بدن می باشد.
اسید آمینه ها واحدی از پروتئین می باشند که بیشتر در فعالیت سلول ها و ارگان های بدنی نقش دارد .
اسید آمینه بیشتر مواقع درون منابع حیوانی گاو و گوسفند قابل مشاهده است.
ترکیبات محیط کشت Asparagine broth
.jpg)
برای دیدن محیط کشت های بیشتر کلیک کنید
طرز تهیه محیط کشت ASPARGENINE BROTH
- 13.5 گرم ASPARGENIN BROTH را در یک لیتر آب مقطر حل کنید.
- 8 میلی لیتر گلیسرول را به محلول اضافه کنید.
- خوب مخلوط کرده و محیط کشت را با حرارت دادن و هم زدن مکرر حل کنید.
- یک دقیقه بجوشانید تا کاملا حل گردد.
- در ظروف مناسب توزیع کنید
- در اتوکلاو در دمای 121 درجه سانتی گراد به مدت 15 دقیقه استریل کنید.
قیمت محیط کشت Asparagine broth
محیط کشت در انواع گوناگون در فروشگاه آنلاین و دارای نماد اعتماد الکترونیکی آریا طب با قیمت مناسب به فروش می رسد می توانید از طریق همین سایت نسبت به خرید اینترنتی این محصولات اقدام نمایید.
آدرس ایمیل شما منتشر نخواهد شد. فیلدهای الزامی علامت گذاری شده اند *